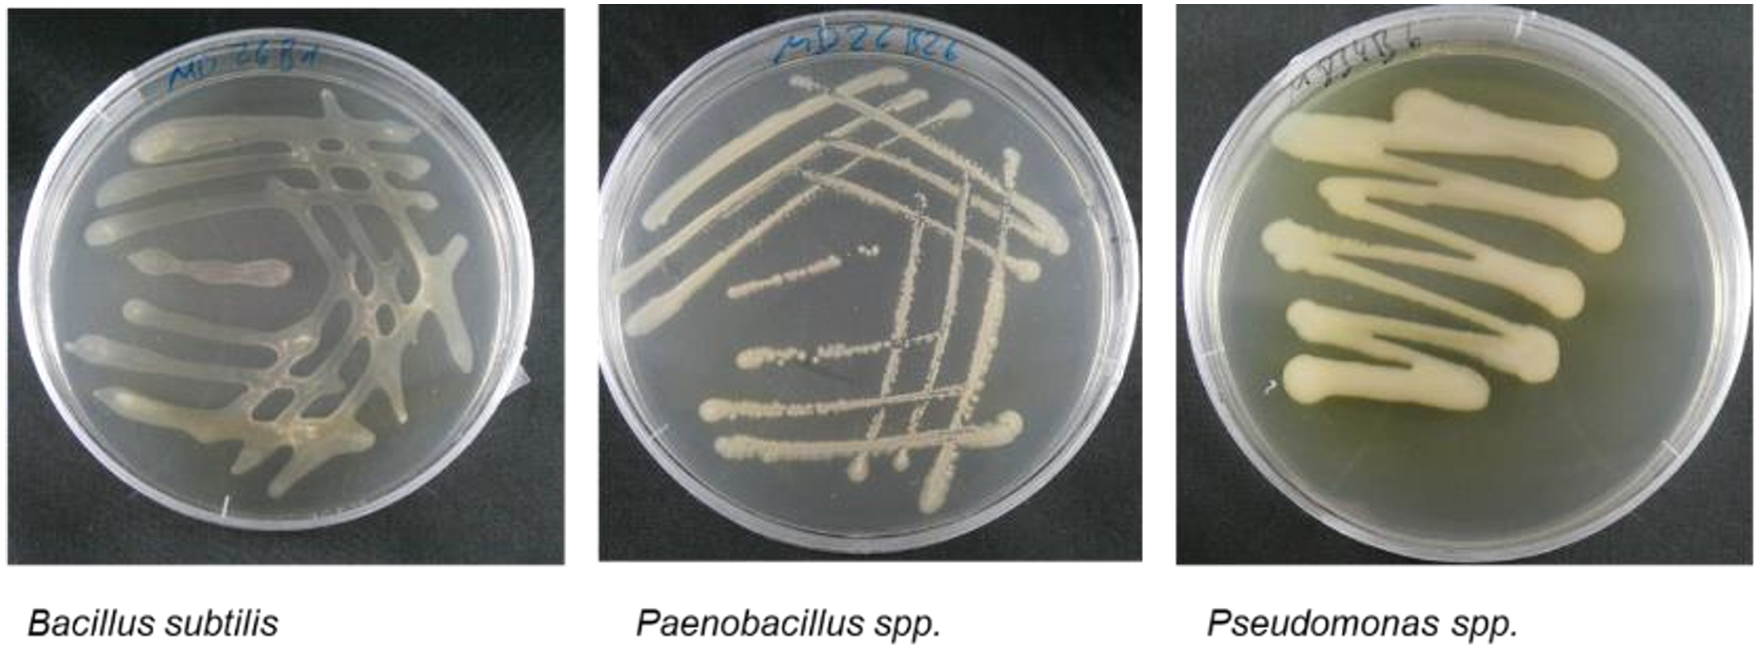

Forschungsergebnisse
Forschungsergebnisse des MykoDeck
Ansprüche an die Abdeckerde
Abdeckerden sind essentiell für die Pilzproduktion und müssen vorrangig folgende Aufgaben erfüllen:
- Wasser speichern
- vor Austrocknung schützen
- Luftfeuchtigkeit im Kulturraum halten
- Fruktifikationsoberfläche für die Kulturpilze bieten
- Gasaustausch durch Krümelstruktur (Mikroklima) erhalten
- wachstumsförderliche Bakterien bereitstellen, wie zum Beispiel Pseudomonas
Vorgehensweise
Im Rahmen des Projekts MykoDeck haben wir von 2021 bis 2024 ausgiebig nach einer torffreien Abdeckerde geforscht und dabei folgende Anstrengungen unternommen:
- 45 Roh- und Reststoffe untersucht, behandelt und analysiert
- 20 Stämme von Kulturpilzen getestet
- 140 Fremdkeime (98 Bakterien und 42 Pilze) molekulardiagnostisch identifiziert
- 95 Isolate (77 Bakterien und 18 Pilze) für Versuche gewonnen
- 120 Mischungen hergestellt und unter Laborbedingungen getestet
- 12 torffreie Rezepturen entwickelt
- Mischungen kleintechnisch hergestellt
- Betriebsversuche mit torffreien und torfreduzierten Mischungen erfolgreich durchgeführt
Betriebsversuche mit torffreier Abdeckerde
Ernteergebnisse
Die untenstehende Tabelle zeigt Ernten aus einer Versuchsreihe im Pilzbetrieb. Als Abdeckerde wurden verwendet: torffreie Mischung nach Rezept 1 und 3 (M1, M3), eine Mischung aus M1 und M3, und drei Kontrollen mit Torf. Die Wochenbeträge zeigen die Champignonernte in Kilogramm pro Quadratmeter Anbaufläche. Die Gesamternte wurde nach zwei und vier Wochen summiert, und der Mittelwert spiegelt die Ernte nach zwei und vier Wochen wieder, gemittelt über die Versuche mit M1, M3 und Torf.
Die torffreien Mischungen M1 und M3 erzielten nach zwei Wochen etwa 90% jener Erntemenge die mit Torf erreicht wurde (Tabelle 1). Dabei erzielten einige Versuche mit torffreier Abdeckerde höhere Ernten als die schlechteste Ausbeute mit Torf. Die Ernteerträge von torfbasierter und torffreier Abdeckerde lassen sich also durchaus vergleichen. Hier ist auch zu bedenken, dass in der Deutschen Champignonproduktion seit über siebzig Jahren fast ausschließlich Torf als Abdeckerde eingesetzt wird. Die komplexen Betriebssysteme mit speziell eingestellten Substraten, Klimaräumen und Erntevorgängen sind daher auf den Anbau mit Torf abgestimmt, während unsere torffreien Mischungen hier zum ersten Mal im Großversuch eingesetzt wurden. Eine zukünftige Einstellung der Produktionsbedingungen auf torffreie Abdeckerden lässt daher noch Entwicklungspotenzial für größere Ernten offen.
Torf & Pilzkrankheiten
Im kommerziellen Pilzbetrieb mit Torf werden für gewöhnlich nur zwei Fruchtwellen von Champignons geerntet. Zum einen nimmt die Erntemenge nach der zweiten Woche stark ab (Tabelle 1), weshalb eine dritte Erntewoche oft kommerziell unrentabel ist. Zum anderen zeigt sich oft schon in der dritten oder vierten Woche ein Befall mit Bakterien oder Fremdpilzen, was zu Krankheitsbildern oder gar Ernteausfällen führen kann. Diese erhöhte Krankheitsanfälligkeit wird häufig mit der hohen Wasserspeicherfähigkeit und Reaktionsoberfläche von Torf in Verbindung gebracht.
Unsere torffreie Abdeckerde bleibt auch in der vierten Erntewelle noch krankheitsfrei und ertragreich. Hierdurch eröffnet sich die Chance, gegenüber torfbasierter Abdeckerde, die Produktionszeit um eine oder zwei Wochen zu verlängern. Entsprechende Versuche mit neuen, ertragsoptimierten Mischungen laufen bereits.
Vollständiger Torfersatz
Unsere Versuche in Pilzbetrieben zeigen, dass die neue, torffreie Abdeckerde sich leicht verarbeiten lässt, und ähnlich hohe Ernteerträge einbringt wie die torfbasierte Abdeckerde. Dabei sind die Betriebsbedingungen auf den Einsatz von Torf optimiert, wodurch sich in unsere Abdeckerde weiteres Entwicklungspotenzial projezieren lässt.
In der Champignonproduktion ersetzt jede Tonne MykoDeck eine Tonne Torf.
MykoDeckPro
Im erweiterten Forschungsprojekt MykoDeckPro schaffen wir die Kapazitäten diese neuen Abdeckerden im Kilotonnenbereich zu erzeugen und damit kommerzielle Pilzzüchter nachhaltig versorgen zu können. Wichtig ist hierbei auch, unser verfahrenstechnisches und biologisches Wissen zu erweitern, so dass Züchter ihre Produktionsverhältnisse auf die Eigenheiten dieser neuen Abdeckerde anpassen können.
Weitere Informationen zur Forschungsweise und detaillierte Beschreibungen der getesteten Rohstoffe finden Sie im Abschlussbericht zum Projekt MykoDeck: